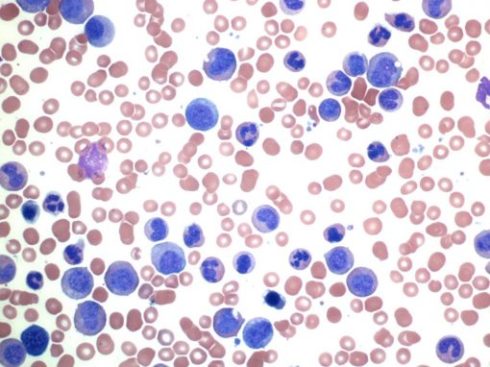
لوسمی میلوئید مزمن
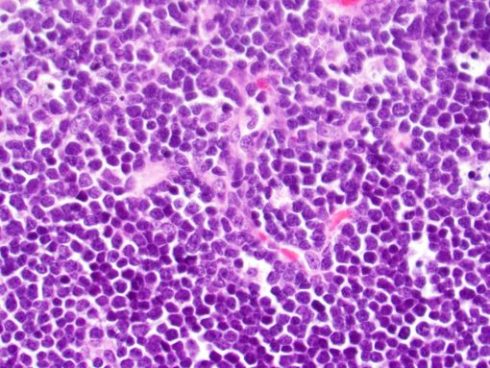

آرشیو دسته بندی: بیماری ها
سرطان مجرای صفراوی (Bile Duct Cancer) چیست؟
مقدمهای بر سرطان مجرای صفراوی سرطان زمانی شروع میشود که سلولهای بدن شروع به رشد[بیشتر بخوانید]
سرطان آندومتر (Endometrial Cancer) چیست؟
سرطان آندومتر (Endometrial Cancer) زمانی شروع میشود که سلولهای آندومتر (پوشش داخلی رحم) شروع به[بیشتر بخوانید]
سرطان استخوان (Bone Cancer) چیست؟
سرطان استخوان (Bone Cancer) اطلاعات موجود در این مطلب بر روی سرطانهای اولیه استخوان (سرطانهایی[بیشتر بخوانید]
2 دیدگاه
سرطان سینه در مردان (Breast Cancer in Men) چیست؟
سرطان سینه (Breast cancer) عمدتاً در زنان رخ میدهد اما مردان نیز ممکن است به[بیشتر بخوانید]
سرطان آدرنال (Adrenal Cancer) یا غدد فوق کلیوی چیست؟
سرطان آدرنال در مورد غدد فوق کلیوی (adrenal glands) آدرنالها غدد کوچکی هستند که بالای[بیشتر بخوانید]
تومورهای مغزی و نخاعی در کودکان (Brain and Spinal Cord Tumors in Children) چیست؟
تومورهای مغزی و نخاعی در کودکان تومورهای مغزی و نخاعی تودهای از سلولهای غیر طبیعی[بیشتر بخوانید]
سرطان مثانه (Bladder Cancer) چیست؟
سرطان مثانه (Bladder Cancer) چیست؟ سرطان مثانه زمانی شروع میشود که سلولهای تشکیل دهنده مثانه[بیشتر بخوانید]
Bigorexia چیست؟ 4 علائم Bigorexia و راههای درمان
Bigorexia که به نام دیسمورفی عضلانی نیز شناخته میشود، یک وضعیت سلامتی است که میتواند[بیشتر بخوانید]
تومورهای مغز و نخاع بزرگسالان (Adult Brain and Spinal Cord Tumors) چیستند؟
تومورهای مغز و نخاع تودهای از سلولهای غیر طبیعی در مغز یا نخاع هستند که[بیشتر بخوانید]
4 دیدگاه
سرطان معده (Stomach Cancer) چیست؟
سرطان معده (Stomach Cancer) چیست؟ سرطان زمانی شروع میشود که سلولهای بدن شروع به رشد[بیشتر بخوانید]
لوسمی دوران کودکی (Childhood Leukemia) چیست؟
سرطان زمانی شروع میشود که سلولهای بدن شروع به رشد خارج از کنترل میکنند. تقریباً[بیشتر بخوانید]
لوسمی حاد میلوئیدی یا AML چیست؟
مقدمهای بر لوسمی حاد میلوئیدی یا AML سرطان زمانی شروع میشود که سلولها در بخشی[بیشتر بخوانید]
سندرم 5q- (5q minus syndrome)
سندرم 5q- (5q minus syndrome) نوعی اختلال مغز استخوان به نام سندرم میلودیسپلاستیک (myelodysplastic syndrome[بیشتر بخوانید]
لوسمی میلومونوسیتی مزمن (Chronic Myelomonocytic Leukemia) چیست؟
مقدمهای بر لوسمی میلومونوسیتی مزمن (Chronic Myelomonocytic Leukemia) لوسمی مزمن میلومونوسیتی (CMML) در سلولهای خون[بیشتر بخوانید]
سندرم کاودن
سندرم کاودن چیست؟ کاودن یک اختلال ژنتیکی است که با تومورهای غیرسرطانی به نام هامارتوم[بیشتر بخوانید]
لوسمی مزمن میلوئیدی (Chronic Myeloid Leukemia یا CML) چیست؟
سرطان زمانی شروع میشود که سلولهای بدن شروع به رشد خارج از کنترل میکنند. تقریباً[بیشتر بخوانید]
سرطانهای خون
سرطانهای خون سرطانهای خون بر تولید و عملکرد سلولهای خونی شما تأثیر میگذارند. بیشتر این[بیشتر بخوانید]
لوسمی لنفوسیتی حاد (ALL یا Acute Lymphocytic Leukemia)
لوسمی حاد لنفوسیتی (ALL) چیست؟سرطان زمانی شروع میشود که سلولهای بدن شروع به رشد خارج[بیشتر بخوانید]
بیماریهای پریون و 7 علائم آن
بیماریهای پریون شرایط مختلفی دارند. پریون نوعی پروتئین است که میتواند سایر پروتئینهای طبیعی در[بیشتر بخوانید]
لوسمی لنفوسیتی مزمن (Chronic Lymphocytic Leukemia) چیست؟
سرطان زمانی شروع میشود که سلولها شروع به رشد خارج از کنترل کنند. تقریباً سلولهای[بیشتر بخوانید]
کمبود بیوتینیداز
نامهای دیگر کمبود بیوتینیداز کمبود BTD کمبود کربوکسیلاز چندگانه نوزادی کمبود کربوکسیلاز چندگانه نوجوانان کمبود[بیشتر بخوانید]